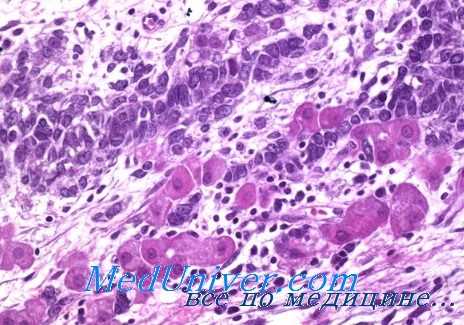
липоидоклеточные опухоли

Липоидоклеточные опухоли - причины возникновения
Добавил пользователь Валентин П. Обновлено: 14.12.2025
Лечение маскулинизирующих опухолей яичника. Дифференциальный диагноз вирильного синдрома
Лечение больных с маскулинизирующей опухолью яичника только оперативное. Практически при арренобластомах, которые обычно встречаются в молодом возрасте, оперативное вмешательство ограничивается удалением пораженного яичника. При этом необходимо учитывать тип арренобластомы (срочная гистологическая диагностика), так как при недифференцированном типе ее злокачественное превращение наблюдается в 3 раза чаще, чем при тубулярной аденоме Пика.
При липоидоклеточных опухолях обычно удаляют матку с придатками, учитывая пожилой возраст больной и возможность злокачественного течения заболевания (21%).
После операции женский облик больной восстанавливается в обратной развитию болезни последовательности, т. е. прежде всего (через 1,5—4 мес) появляются менструации (если матка не удалена), исчезает атрофия молочных желез, уменьшается гирсутизм. Такие симптомы, как увеличение клитора, огрубение голоса и гирсутизм, могут сохраниться в течение всей жизни.
После операции возможно наступление беременности, завершающейся нормальными родами. Уровень 17-КС мочи всегда снижается до нормы.
Прогноз в большей части случаев благоприятный, однако у 12—22% больных наблюдаются рецидивы опухоли, причем иногда через 12 лет [Morris, Scully].

Дифференциальный диагноз вирильного синдрома
При наличии вирильного синдрома у женщины прежде всего нужно выяснить его генез. Практическому врачу чаще всего приходится дифференцировать вирильный синдром яичникового происхождения от адреногенитального. Это имеет большое значение, так как методы лечения определяются генезом заболевания.
При надпочечниковом генезе вирильного синдрома в анамнезе могут быть указания на затруднения при определении пола после рождения, чрезмерно быстрый рост в раннем детстве с последующей его остановкой, отсутствие менструаций, а иногда ложное преждевременное половое созревание. При яичниковом генезе вирильного синдрома имеются указания на появление симптомов маскулинизации у совершенно здоровой женщины с нормально развитыми вторичными половыми признаками, своевременным наступлением менструаций и телосложением по женскому типу.
При осмотре больной с вирильным синдромом надпочечникового генеза обращает на себя внимание мужской тип телосложения с хорошо развитой мускулатурой и шириной плеч, превышающей расстояние между большими вертелами бедер. Иногда гирсутизм бывает выражен чрезмерно, имеет универсальный характер и у некоторых больных сочетается с облысением, а при болезни Иценко — Кушинга — с ожирением туловища и лунообразным лицом. При осмотре наружных половых органов отмечается мужской тип оволосения, гипертрофия клитора. Это всегда указывает на врожденный адреногенитальный синдром.
При вирилыюм синдроме яичникового генеза гирсутизм обычно бывает значительно меньше выражен, чем при синдроме надпочечникового происхождения [Пенчев И., Green]. У больной отмечается правильное телосложение с нормально развитыми вторичными половыми признаками. Иногда при синдроме поликистозных яичников наблюдается замедленное развитие молочных желез, а при арренобластоме яичника — атрофия.
Клиническая картина вирильного синдрома, обусловленного гиперплазией коры надпочечников, характеризуется постепенным развитием симптомов вирилизации и умеренной их выраженностью. При опухоли надпочечника наблюдается быстрое прогрессирование симптомов заболевания. Особенно быстро признаки вирилизации прогрессируют при злокачественных опухолях коры надпочечника [Пенчев И., 1962; Мамедов А. З.].
При андростероме обычно выражены симптомы вирилизации без обменных нарушений, а при кортикостероме происходит избыточное образование глюкокортикоидов и часто минералокортикоидов. В связи с этим могут развиваться ожирение туловища, гипертония, стероидный диабет, остеопороз, изменение окраски кожи, появление полос растяжения. В коре надпочечника нередко возникают опухоли смешанного характера, при которых наряду с симптомами вирилизации можно наблюдать и обменные нарушения.
Для уточнения диагноза производят рентгенографию в условиях ретропневмаперитонеума или пневморен с томограммой, что дает возможность обнаружить гиперплазию или опухоль надпочечника. Иногда при опухоли надпочечника происходит смещение соответствующей почки, что имеет определенное диагностическое значение [Преображенский А. П., Арапов Д. А.]. Это чаще наблюдается при злокачественных опухолях коры надпочечника, которые нередко достигают больших размеров [Николаев О. В., Тараканов Е. И.].
При подозрении на болезнь Иценко — Кушинга рекомендуется произвести снимок турецкого седла.
ЛИПИДОКЛЕТОЧНЫЕ ОПУХОЛИ
Липидоклеточные опухоли (син. липоидоклеточные опухоли, уст. син. овомаскулинома) — группа опухолей яичника неясного или сомнительного генеза, содержащих большое количество липохромного пигмента, объединенных одним термином на том основании, что все они состоят из клеток с типичной для стероидпродуцирующих клеток морфологией.
В 1939 г. для группы овариальных опухолей, сопровождающихся маскулинизацией, Роттино и МакГратом (A. Rottino, J. McGrath) был предложен термин «овомаскулинома». По современной классификации новообразований яичников, принятой ВОЗ (1973), опухоли этой группы относят к категории липидоклеточных опухолей.
К Липидоклеточным опухолям относят опухоли, исходящие из дистопированного коркового вещества надпочечников, из хилусных клеток яичника, а также лютеомы, которые разделяют на стромальные лютеомы и, если женщина беременна,— лютеомы беременности.
Этиология и гистогенез не установлены.
Патологическая анатомия
Липидоклеточные опухоли лишены топографических и микроскопических особенностей, которые необходимы для их идентификации.
Опухоль из дистопированного коркового вещества надпочечника — редкая опухоль яичников; встречается в любом возрасте, даже у девочек. Большей частью опухоль односторонняя, может достигать больших размеров и имеет форму четко очерченного узла охряно-желтого цвета. Подобно клеткам коркового вещества надпочечников, опухолевые клетки формируют обильно васкуляризированные тяжи и колонки. Цитоплазма клеток богата липидами, гл. обр. свободным и связанным холестерином. На гистол, препаратах цитоплазма выглядит пенистой, как бы пустой; ядра большей частью маленькие, гиперхромные.
Опухоль из клеток хилуса возникает в любом возрасте, но чаще между 40 и 50 годами. Обычно опухоль односторонняя, локализуется в области ворот яичника, на разрезе желтого цвета различных оттенков; как правило, небольшого размера. Патогномоничным для этого типа опухоли считается присутствие кристаллоидов Рейнке в цитоплазме опухолевых клеток, хотя даже лейдигомы яичек только в 40% случаев имеют эти цитоплазматические включения. Опухолевые клетки имеют обильную оксифильную, интенсивно красящуюся цитоплазму, мелкозернистую или гомогенную; в ней содержится различное количество липидов типа свободного и связанного холестерина. Опухолевые клетки формируют обширные поля, между к-рыми проходят тяжи рыхлой соединительной ткани с большим количеством кровеносных сосудов; клеточные границы могут быть плохо различимы.
Стромальная лютеома — редкая опухоль яичника, встречается чаще у женщин в период менопаузы. Опухоль располагается в толще коркового слоя яичника, состоит из лютеинизированных клеток межуточной ткани коркового слоя яичника с обильной цитоплазмой, к-рая в процессе гистологической обработки ткани вакуолизирована в различной степени за счет растворения цитоплазматических липидов (преимущественно холестерина). Опухоли обычно множественные, часто двусторонние, нередко сопровождаются явлениями стромального текоматоза яичников, или так наз. гипертекоза.
Лютеома беременности возникает только в период беременности, чаще у многорожавших женщин. Источником опухоли могут быть не только лютеинизированные стромальные клетки, но и тека-лютеиновые клетки атретических фолликулов, стимулированные хорионическим гонадотропином. Узлы при лютеоме беременности следует рассматривать скорее как результат очаговой гиперплазии лютеинизированных стромальных и тека-клеток, а не как истинную опухоль, поскольку после родов узлы подвергаются инволюции и утрачивают гормональную активность.
Клиническая картина
Клиническая картина однотипна, поскольку Липидоклеточные опухоли в основном обладают выраженной андрогенной активностью и вызывают Вирильный синдром (маскулинизацию женщины) в результате чрезмерной секреции опухолью андрогенов (см.). Опухоли из эктопированного коркового вещества надпочечников могут секретировать также избыточное количество кортикостероидов (см.). Картина заболевания характеризуется расстройством менструального цикла (см.) по типу опсо- или аменореи, первичным или вторичным бесплодием (см.), вирилизацией (см.) — увеличением клитора, оволосением на лице и теле по мужскому типу, огрубением голоса. В ряде случаев (при избыточном образовании кортикостероидов) может развиться синдром Кушинга (см. Кушинга синдром) и гиперостоз лобных костей, у детей — синдром преждевременного полового созревания (см. Гипергонадизм).
У больных с опухолью из дистопированного коркового вещества надпочечников обнаруживается повышенное (в 2—5 раз) содержание 17-кетостероидов в суточной моче. У больных с опухолью из хилусных клеток и лютеомами наблюдается резкое повышение уровня тестостерона в плазме периферической крови и в крови, оттекающей от яичника на стороне опухоли. Иногда встречаются Л. о., вырабатывающие чрезмерное количество эстрогенов, которые сопровождаются клин, картиной гиперэстрогенизма. Описаны случаи гормонально-неактивных опухолей без эндокринной клин, симптоматики.
По течению Липидоклеточные опухоли в основном доброкачественные. Злокачественные варианты встречаются среди опухолей из дистопированного коркового вещества надпочечника.
Диагноз (предположительный) ставят на основании вирильного синдрома и данных лабораторного исследования уровня экскреции 17-кетостероидов и их фракций с мочой, а также уровня тестостерона в плазме крови. Для установления источника избыточного образования андрогенов применяют пробу с торможением функции коркового вещества надпочечников дексаметазоном (см. Дексаметазоновая проба) и стимуляцией на этом фоне функции яичников хорионическим гонадотропином (см.). Для топической диагностики проводят рентгенографическое исследование органов малого таза: пневмопельвиорентгенографию (см. Пельвиграфия) или тазовую ангиографию (см.). Дифференцировать Л. о. приходится с опухолями коркового вещества надпочечников (см.), вирилизирующими гормонально активными опухолями яичников (см.), а также с текоматозомяичников, сопровождающимся развитием вирильного синдрома. Несмотря на то что гистогенез Л. о. еще не может быть достоверно установлен, делаются попытки разграничения опухолей этой группы. Так, если у женщины с вирильным синдромом овариального генеза обнаружена опухоль в области широкой связки матки или ворот яичника, можно думать об опухоли из дистопии коркового вещества надпочечника, поскольку в этих местах могут располагаться эктопированные адреналовые клетки. Решающим в установлении диагноза является патогистол, исследование удаленной опухоли с учетом ее локализации.
Лечение и Прогноз
Лечение оперативное, за исключением лютеом беременности, которые после родов подвергаются инволюции. Операция должна быть щадящей: удаляют только опухоль, сохраняя по возможности здоровую ткань яичника.
Прогноз благоприятный — удаление опухоли сопровождается исчезновением всех клин, проявлений заболевания. Даже в случае злокачественной опухоли своевременно проведенная операция дает благоприятный исход; рецидивы и метастазы наблюдаются крайне редко.
Библиография: Глазунов М. Ф. Опухоли яичников, с. 259, Л., 1961; Руководство по патологоанатомической диагностике опухолей человека, под ред. Н. А. Краевского и А. В. Смольянникова, с. 258, М., 1976; Старкова H. Т. Основы клинической андрологии, М., 1973; Norris H. J. а. Сhоrltоn I. Functioning tumors of the ovary, Clin. Obstet. Gynec., v. 17, p. 189, 1974; Norris H. J. a. Taylor H. B. Nodular theca-lutein hyperplasia of pregnancy (so-called «pregnancy luteoma»), Amer. J. clin. Path., v. 47, p. 557, 1967; Roth L. M. a. Sternberg W. H. Ovarian stromal tumors containing Leidig cells, Cancer, v. 32, p. 952, 1973; Scully R. E. Ovarian tumors, Amer. J. Path., v. 87, p. 686, 1977; Serov S. F., Scully R. E. a. Sobin L. H. Histological typing of ovarian tumours, Geneva, WHO, 1973.
Липома, или жировик
Информацию из данного раздела нельзя использовать для самодиагностики и самолечения. В случае боли или иного обострения заболевания диагностические исследования должен назначать только лечащий врач. Для постановки диагноза и правильного назначения лечения следует обращаться к Вашему лечащему врачу.
Липома: причины появления, симптомы, диагностика и способы лечения.
Определение
Липома – это часто встречающаяся опухоль, состоящая из жировых клеток (адипоцитов) и обычно отграниченная от окружающих тканей тонкой соединительнотканной капсулой. Липомы могут образовываться в любом месте, где присутствуют жировые клетки, обычно располагаются подкожно, но иногда обнаруживаются на внутренних органах (например, в желудке, пищеводе или кишечнике, бронхах, сердце или в мышцах).
Липомы представляют собой доброкачественные новообразования, не имеют тенденции к озлокачествлению и не доставляют дискомфорта пациентам. Исключение составляют те случаи, когда липомы неудачно расположены (например, в области сустава) или быстро растут, что случается крайне редко.
Липомы – наиболее распространенные мезенхимальные опухоли (мезенхимальные опухоли – это опухоли мягких тканей и специфические опухоли костей). Заболеваемость составляет порядка 2,1 на 1000 человек в год, причем у мужчин диагностируется несколько чаще, чем у женщин.
Причины возникновения липомы
Точные причины развития липом неизвестны. Некоторые исследователи сходятся во мнении, что в их формировании играют роль генетические аномалии. Другая теория предполагает наличие связи между возникновением липомы и предшествующей травмой. Факторами риска развития липомы могут стать ожирение, злоупотребление алкоголем, заболевания печени, нарушение толерантности к глюкозе, гиперлипидемия. Появление липомы может стать следствием другого заболевания, например, семейного множественного липоматоза.
Классификация заболевания
Липомы бывают простыми и множественными (множественный липоматоз). К последним относятся болезнь Деркума, доброкачественный симметричный липоматоз (болезнь Маделунга), семейный липоматоз, врожденный инфильтрирующий липоматоз. Множественные липоматозы составляют примерно 5-10% от всех выявляемых случаев липом.
В зависимости от того, компоненты каких тканей вовлечены в патологический процесс, выделяют фибролипомы (с соединительнотканными элементами), миолипомы (в составе есть мышечные волокна), ангиолипомы (включают сосуды), миксолипомы (содержат слизистую ткань), миелолипомы (содержат кроветворные ткани).
Симптомы липомы
Липомы в подкожной жировой клетчатке на ощупь мягкие и подвижные, не спаянные с окружающими тканями. Липомы характеризуются медленным ростом, а их размер обычно составляет от 1 до 10 см. Липомы большего размера называются «гигантскими». Образования обычно безболезненные, если не затрагивают суставы, нервы или кровеносные сосуды. Кожа над липомой не изменена.

В желудочно-кишечном тракте липомы представляют собой подслизистые жировые опухоли. Они протекают бессимптомно, но способны провоцировать изъязвления и кровотечение. Липомы пищевода могут затруднять проглатывание пищи и жидкости, вызывать отрыжку, рвоту и рефлюкс.
Липомы тонкой кишки диагностируются, как правило, у пожилых людей, чаще всего располагаются в подвздошной кишке и опасны закупоркой (обтурацией) просвета кишечника.
Помимо того, липомы кишечника вызывают боль, обструктивную (механическую) желтуху и инвагинацию кишечника (внедрение одной части кишечника в другую).
Крайне редко липомы формируются в сердце: субэндокардиально – под внутренней выстилкой сердца (эндокардом) или интрамурально – внутри мышечного слоя (миокарда). Обычно сердечные липомы не покрыты капсулой, выглядят как желтая масса, выступающая в полость сердца. Липомы сердца могут стать причиной боли в груди, аритмии и одышки.
Диагностика липомы
Для постановки диагноза требуется клинический осмотр врачом и проведение ультразвукового исследования мягких тканей.
Исследование мягких тканей для выявления патологических изменений и диагностики новообразований.
Липоидоклеточные опухоли - причины возникновения
Клиника и диагностика липоидоклеточных опухолей
Средний возраст больных с липоидоклеточной опухолью 47 лет. Липоидоклеточные опухоли яичника отличаются медленным ростом и постепенным развитием симптомов маскулинизации. В связи с небольшими размерами (иногда 1—2 см в диаметре) опухоль не всегда пальпируется и диагноз длительно не устанавливается [Israel]. Из-за небольших размеров опухоли редко вызывают боли (13%). асцит [Pedowitz, Pomerance].
При клиническом анализе 58 больных с адреналоподобной опухолью яичника, описанных в литературе, удалось установить, что у значительного большинства их (48) дефеминизация началась с внезапно наступившей аменореи, гирсутизм появился у 54 огрубение голоса — у 41 [Pedowitz, Pomerance].
При развитии заболевания у девочки может наступить ложное преждевременное половое созревание. Наличие адреналоподобной опухоли яичника у взрослой женщины вызывало, кроме симптомов вирилизации, появление гипертонии (в 47% случаев), нарушение углеводного обмена (в 40%), развитие ожирения (в 37%).
Опухоли из гилюсных клеток, как правило, встречаются только у пожилых женщин в период менопаузы в возрасте от 46 до 86 лет [Jakobovits]. Они часто бывают очень маленьких размеров (1—3 см в диаметре), располагаются обычно в области гилюса яичника, поэтому не всегда пальпируются. Клинически опухоли лейдиговых клеток характеризуются появлением симптомов вирилизации различной интенсивности [Langa et al.].
Эти симптомы обусловливаются способностью липоидоклеточных опухолей, так же как и арренобластомы, синтезировать тестостерон [Sandberg et al.].

Для опухолей из лейдиговых клеток характерно медленное развитие, что обусловливает большую длительность заболевания, иногда 18—32 года [Sternberg].
Уровень 17-КС мочи при этих опухолях повышен незначительно (до 25 мг в сутки). В то же время необходимо отметить, что иногда гиперплазия гилюсных или лейдиговых клеток вызывает гиперплазию эндометрия.
Диагностика липоидоклеточных опухолей. Диагноз маскулинизирующей опухоли яичника ставится на основании появления симптомов вирилизации и обнаружения опухоли яичника, обычно подвижной, плотной консистенции, сохраняющей его форму. При гормональном исследовании часто отмечается увеличение экскреции 17-КС мочи при нормальном количестве ДЭА. Фракционное определение 17-КС мочи указывает на повышение андростерона и этиохоланолона. В то же время 17-КС мочи при маскулинизирующих опухолях яичника могут оставаться в пределах нормы. Проба с дексаметазоном не вызывает снижения их уровня. Исключением в этом отношении является адреналоподобная опухоль.
Иногда для уточнения диагноза используют лапароскопию или гинекографию, которые позволяют обнаружить опухоли яичника небольших размеров. Иногда диагноз маскулинизирующей опухоли яичника при наличии вирильного синдрома ставится на основании исключения других причин вирилизации из-за незначительных размеров. Согласно данным литературы, 1/3 маскулинизирующих опухолей при влагалищном исследовании не пальпируется.
Нужно также иметь в виду, что маскулинизирующие опухоли яичника типа арренобластомы обычно встречаются у женщин детородного возраста [Jakobovits], появление же симптомов вирилизации в период менопаузы заставляет предположить наличие крайне редко встречающейся липоидоклеточной опухоли яичников.
Термином «липоидоклеточные опухоли» принято обозначать опухоли, состоящие из больших округлых и многогранных клеток, которые содержат много липоидов и похожи на клетки Лейдига, лютеиновые клетки и клетки коры надпочечника. Гистологическое сходство между ними настолько велико, что дифференцировать их не всегда возможно [Morris, Scully, Scully].
Липоидоклеточные опухоли встречаются очень редко и только в 50% случаев обладают андрогенным действием [Scully]. Они обычно односторонние, средних размеров, имеют солидное строение, но иногда возможно их кистозное перерождение. Цвет опухоли в зависимости от содержания липоидов желтый, оранжевый или красновато-коричневый.
Эти опухоли не всегда имеют капсулу и иногда бывают окружены атрофической или фиброзной стромой яичников. Липоидоклеточные опухоли небольших размеров, обычно располагаются в области гилюса и трактуются как опухоли их клеток Лсйдига. Опухоли больших размеров, находящиеся в корковом слое яичника, обычно считают лютеомой или интерстициомой. Адреналоподобные опухоли не имеют капсулы и часто располагаются в области широкой связки.
Одни авторы [Scully] считают их источником дистопированные клетки коры надпочечника, другие — тека-лютеиновые клетки.
Происхождение липоидоклеточных опухолей из дистопированных клеток коры надпочечника подтверждается наличием в ряде случаев, кроме симптомов вирилизации, повышения артериального давления, ожирения, диабета и других признаков синдрома Кушинга [Scully]. В биохимическом отношении они стоят ближе к опухоли надпочечника, чем яичника, так как вызывают резкое повышение 17-КС мочи (до 257 мг в сутки) и ДЭА [Scully].
Teilum рассматривает адреналоподобные опухоли как результат пролиферации потенциально лейдиговых клеток, дифференцированных из мезенхимы гонады, и других клеточных элементов типа тека-клеток. Иначе говоря, этот автор предлагает рассматривать адреналоподобные опухоли яичника как вариант арренобластомы (диффузная андробластома) с развитием только лейдиговых клеток. М. Ф. Глазунов допускает возможность трактовки опухоли из лейдиговых клеток как «гипернефромы» или «лютеомы».
В связи с трудностью, а иногда и невозможностью дифференциального диагноза при липоидоклеточных опухолях яичника некоторые авторы [Teter, Bulski] предлагают все вирилизирующие опухоли яичника, происходящие из интерстициальных клеток, называть «интерстициомой» независимо от того, в каком направлении дифференцируются клетки мезенхимы яичника (в лейдиговы клетки, в мозговом слое яичника или в тека-лютеиновые клетки в его корковом слое). Эти авторы адреналоподобную опухоль яичника также предлагают называть «интерстициомой». Однако более принято эту группу маскулинизирующих опухолей называть липоидоклеточными.
Читайте также:
